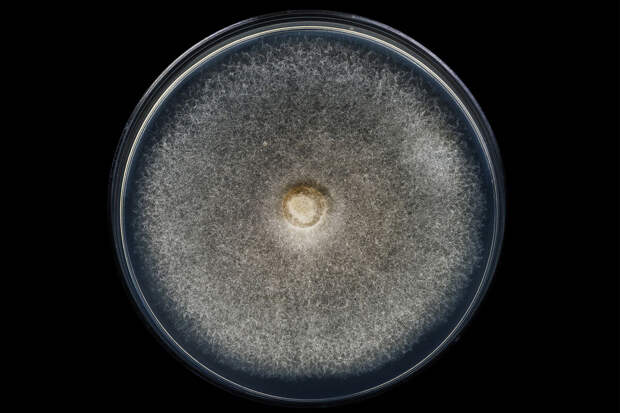

Ученые из Йельского университета (США) научились останавливать рост раковой опухоли с помощью методики редактирования генов CRISPR. Об этом сообщает "Ридус". Уточняется, что исследователи удалили лишние хромосомы из поврежденных клеток и обнаружили, что это позволяет остановить бесконтрольный рост опухоли.
Специалисты отмечают, что здоровые человеческие клетки насчитывают 23 пары хромосом. При этом у большинства раковых клеток есть дополнительные пары. Ученые создали уникальный инструмент при помощи CRISPR, а затем устранили с его помощью лишние хромосомы. В итоге клетки потеряли способность генерировать злокачественные опухоли.
В университете отметили, что это лишь первая стадия исследования, все тесты проводились в чашке Петри. При этом, по словам ученых, уже ведется подготовка к испытаниям на животных.
Ранее ученые назвали опасные продукты, провоцирующие развитие рака.
Свежие комментарии